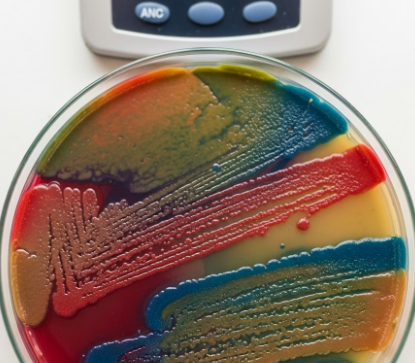

반응형

2025 식중독 예방법과 예방 식단
실생활 체크리스트
실생활 체크리스트
여름만 되면 꼭 뉴스에 한 번쯤 나오는 식중독 사고, 저도 가족과 여행 중에 갑작스레 식중독 증상을 겪었던 적이 있어요. 그때 실제로 “내가 뭘 잘못 먹었나?”라는 생각에 음식 보관법부터 위생까지 다시 돌아보게 되더라고요. 식중독은 예방이 가장 중요하고, 한두 가지 습관만 바꿔도 확실히 안전해질 수 있습니다. 이번 글에서는 경험을 바탕으로 2025년 최신 실생활 기준 식중독 예방법, 실제로 효과 봤던 예방 식단까지 꼼꼼하게 카드형 목차로 준비했습니다. 이 글 한 편으로 여름철 건강, 든든하게 지켜보세요!
1️⃣ 식중독, 왜 여름에 급증할까? 2️⃣ 식중독 예방법 7가지 실전 체크리스트 3️⃣ 예방 식단 & 실생활 식품 관리법 4️⃣ 현장에서 바로 쓰는 위생 꿀팁 5️⃣ FAQ – 궁금증 싹 해소! 6️⃣ 마무리·연관 링크·태그
식중독, 왜 여름에 급증할까?

💡 TIP! 실온에 2시간 이상 둔 음식, 냉장고 자주 여닫는 습관, 익히지 않은 해산물·육류가 식중독 주범!
| 발생 원인 | 사례 | 예방 포인트 |
|---|---|---|
| 상한 음식 | 찌개·반찬 상온 방치 | 2시간 내 냉장보관 |
| 오염된 조리도구 | 칼·도마·행주 교차 사용 | 육류/채소 분리, 소독 |
| 덜 익힌 육류·해산물 | 회, 반숙계란 등 | 충분히 익혀 먹기 |
식중독 예방법 7가지 실전 체크리스트
수년간 식중독을 피해오며 느낀 건, 거창한 방법보다 “작은 습관”이 더 효과적이란 점이에요. 저도 아래 7가지만 실천하면 여름철에도 안심할 수 있었습니다.
- 손 씻기 생활화 – 외출 후, 화장실 사용 후, 조리 전후 30초 이상 꼼꼼히
- 음식은 반드시 익혀 먹기 – 특히 고기·해산물은 중심까지 완전 익힘
- 2시간 내 냉장 보관 – 상온 방치 금지, 여름엔 1시간 이내 추천
- 조리도구 분리·소독 – 칼·도마, 행주 채소/육류 용도 구분
- 생수·끓인 물만 사용 – 얼음도 안전하게 만든 것만
- 유통기한·보관법 꼼꼼히 확인 – 포장 음식도 방심 금지
- 집밥·외식 모두 위생 체크 – 외식/배달도 위생 상태 한 번 더 확인
💡 체크! 가족·아이·노약자와 함께 사는 집이라면 특히 더 꼼꼼하게 체크리스트를 실천해보세요. 한 번 익숙해지면 생활 습관이 됩니다.
| 예방수칙 | 난이도 | 효과 |
|---|---|---|
| 손 씻기 | ★☆☆☆☆ | ⭐⭐⭐⭐⭐ |
| 음식 익혀먹기 | ★★☆☆☆ | ⭐⭐⭐⭐ |
| 조리도구 분리 | ★★★☆☆ | ⭐⭐⭐ |
예방 식단 & 실생활 식품 관리법



- 아침: 계란찜, 바나나, 삶은 감자 – 부드럽고 안전한 조합
- 점심: 완전히 익힌 고기·닭가슴살, 채소볶음 – 고기는 반드시 익혀서!
- 저녁: 밥, 된장국, 데친 채소 – 간단하지만 위생적으로 준비
- 간식: 견과류, 플레인 요거트(유통기한 확인 필수)
- 음료: 끓인 물, 생강차, 보리차 – 얼음도 집에서 직접 만든 것만 사용
💡 실전관리: 남은 반찬은 한 끼 분량씩 소분해 냉장, 냉동. 배달음식 먹을 땐 위생 상태 꼭 체크!
| 실생활 팁 | 적용 방법 |
|---|---|
| 냉장고 자주 정리 | 유통기한 지난 식품 버리기, 정기 소독 |
| 조리도구 세척 | 육류·채소 용도별 구분, 열탕 소독 |
| 식탁 위생관리 | 행주·수건 자주 삶기, 젖은 행주 바로 교체 |
현장에서 바로 쓰는 위생 꿀팁
여름철만 되면 가족, 특히 아이가 있는 집에서 “이 정도까지 해야 해?” 싶을 정도로 위생에 예민해지는 것도 다 이유가 있습니다. 저도 아래 팁을 실천하면서 식중독 걱정이 훨씬 줄었어요.
- 반찬·국은 한 번 데워서 먹기, 상온 방치 최소화
- 배달·포장음식은 받자마자 냉장/재가열, 오래 두지 않기
- 행주·수건은 하루 1회 삶아 소독, 젖은 채 오래 두지 않기
- 채소·과일은 먹기 직전 흐르는 물에 깨끗이 세척
- 아이·노약자 식기는 별도 소독, 젖병은 열탕 소독 필수
- 냉장고 온도(4도 이하)·냉동실(-18도 이하) 수시 체크
💡 현장 꿀팁! 직접 실천해보면 ‘이 정도까지?’ 싶지만, 한두 번만 습관 들이면 가족 건강 지키는 데 정말 효과 만점이에요.



✨ 여름 식중독, 왜 집밥에서도 생기나요?
💡 여름엔 실온 보관만 해도 세균 번식이 빨라져 집밥도 안심할 수 없어요. 위생과 보관법을 꼭 지키세요!
✨ 조리도구 분리는 꼭 해야 하나요?
💡 네! 육류·채소용 칼, 도마를 구분해야 교차 오염을 막을 수 있습니다.
✨ 얼음이나 생수도 식중독 위험이 있나요?
💡 얼음도 오염될 수 있어요. 집에서 끓인 물로 만든 얼음이 가장 안전합니다.
✨ 배달음식 먹어도 되나요?
💡가능하지만, 오래 두지 말고 받자마자 위생 상태와 신선도 체크는 필수!
✨ 외식할 때 위생은 어떻게 확인하나요?
💡 조리 환경, 손 씻기, 음식 상태 한 번 더 확인! 불편해도 나와 가족 건강을 위해 꼼꼼히 체크하세요.
작은 습관이 식중독 예방의 시작!
식중독은 멀리 있는 위험이 아니라, 우리 일상 속에서 항상 주의해야 할 건강 이슈입니다. 저도 실생활에서 예방수칙을 꾸준히 지킨 뒤로 여름철 식중독 걱정이 크게 줄었어요. 여러분도 오늘부터 한두 가지 실천만 시작해도 가족 건강을 훨씬 든든하게 지킬 수 있습니다. 더 궁금한 점이나 경험담, 댓글로 자유롭게 공유해 주세요!
태그: 식중독, 식중독 예방법, 예방 식단, 식중독 증상, 여름 식중독, 가족 위생, 식품 안전, 냉장고 관리, 2025 건강, 여름 건강관리
반응형

